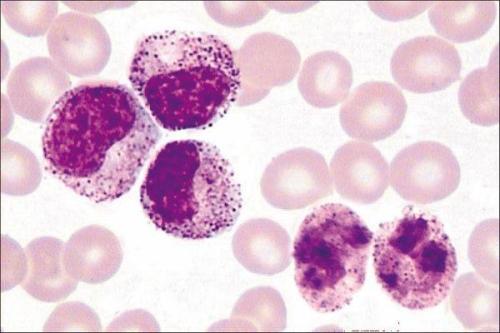
人外周血白血病T细胞 ；Jurkat细胞

人外周血白血病T细胞 ;Jurkat细胞
Jurkat Cells
¥800
1EA
起订
上海 更新日期:2026-04-05
产品详情:
- 中文名称:
- 人外周血白血病T细胞 ;Jurkat细胞
- 英文名称:
- Jurkat Cells
- 保存条件:
- 37℃,5% CO2,无菌恒温培养。
- 产品类别:
- 细胞系
公司简介
生工生物工程(上海)股份有限公司(简称:生工生物)成立于2003年。自成立以来,生工生物始终致力于提供生命科学产品与技术服务,十一年来,生工生物与中国的生命科学事业共同发展, 我们的产品质量愈来愈好,种类愈来愈丰富。我们为广大研发人员提供了高性价比的生命科学实验解决方案,为中国的生命科学事业做出了自己的贡献。今天,中国的生命科学企业如雨后春笋般茁壮成长起来,形成百花争放的良好形势,生工生物不满足于现状,希望走出中国,走向世界,把生工生物建设成为一家国际化、全球化的世界级生命科学企业。
| 成立日期 | (23年) |
| 注册资本 | 18000.000000万人民币 |
| 员工人数 | 50-100人 |
| 年营业额 | ¥ 100万以内 |
| 经营模式 | 试剂,服务 |
| 主营行业 | 抗体,细胞培养,蛋白组学,细胞生物学,诊断试剂 |
人外周血白血病T细胞 ;Jurkat细胞相关厂家报价
-

- Jurkat Cells(赠送Str鉴定报告)|人急性T淋巴细胞白血病细胞
- 上海冠导生物工程有限公司 VIP
- 2026-04-11
- 询价
-

- Jurkat Cells:人急性T淋巴细胞白血病细胞系
- 上海弘顺生物科技有限公司 VIP
- 2026-04-11
- 询价
-

- Jurkat Cells人T淋巴细胞白血病细胞长期复苏|带STR图谱
- 上海宾穗生物科技有限公司
- 2025-12-31
- 询价
-

- Jurkat Cells|人急性T淋巴细胞白血病悬浮细胞
- 上海弘顺生物科技有限公司 VIP
- 2026-04-11
- 询价
-

- Jurkat Cells人T淋巴细胞白血病细胞专业复苏|STR图谱
- 上海宾穗生物科技有限公司
- 2025-12-31
- 询价
-

- Jurkat Cells人T淋巴细胞白血病细胞ATCC保种|STR图谱
- 上海宾穗生物科技有限公司
- 2025-12-31
- 询价
-

- Jurkat Cells人T淋巴细胞白血病细胞复苏率高|STR图谱
- 上海宾穗生物科技有限公司
- 2025-12-31
- 询价